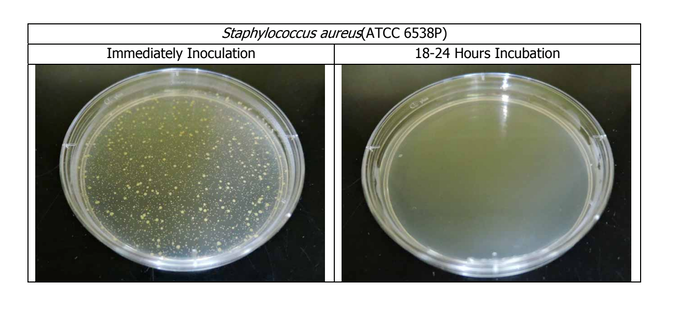

KOUP 環保機能肉桂衣|短袖女款
【兩件免運】款式任選,兩件免運送到家,自己穿、送親友,都划算
KOUP 環保機能肉桂衣
抗臭.快乾.透氣
給你一整天的清爽舒適
★ kickstarter 編輯精選專案
★ 募資上線一小時內達標,達成率超過 500%
天然抗臭|專利肉桂萃取物技術,長效抗菌抗臭
吸濕排汗|客製化紗線,只要 17 分鐘就乾
涼爽透氣|特殊織造技術,涼感透氣不黏膩
極致輕量|重量不到 100g,全日穿著無負擔
*KOUP 機能肉桂衣、口罩為廠商獨立出貨,請與其他商品分開結帳唷!若您的訂單內有商店內的其他商品,將導致運費計算有誤,客服會協助取消訂單,請您另外下單。造成不便,還請諒解!
促銷活動
你穿的排汗衣,是否很容易就讓你全身都是令人不愉快的汗臭味?
想穿不臭,你可能會想到羊毛衣,但畢竟不是每個人都穿的住、或是能接受羊毛的製品的呀!
難道,只能默默忍受汗臭嗎?
有了 KOUP,你將有全新的選擇!▽ ▽ ▽
來自英國的設計品牌 KOUP,要用全世界最迷人的香料——肉桂,顛覆你對排汗機能衣的想像!
🔥 kickstarter 募資一小時內達標,專案達成率超過 500%!
🔥 kickstarter 編輯推薦(Project We Love)專案
你知道嗎?流汗會臭,是因為汗水裡的油脂與蛋白質,接觸到皮膚上繁殖的細菌,被分解後所產生的異味。
而肉桂獨特的辛香氣息,來自一種名為「桂皮醛」(Cinnamonaldehyde)的醛類有機化合物,很早就被發現具有抗氧化、抑制細菌生長的作用。
KOUP 環保機能肉桂衣,便是利用專利技術,將肉桂萃取物,加進可循環再利用的寶特瓶紗,並透過特殊織造技術,製成一件抗菌、吸濕排汗、透氣涼感的機能衣!
看到這裡,你一定想問——「那衣服會有肉桂味嗎?」
別擔心(或者,別傷心)!KOUP 肉桂衣使用的是天然肉桂萃取物,並不是直接把肉桂加到衣服裡,因此聞起來就跟正常的衣服一樣,而且——即使在流汗過後也一樣乾爽無異味!
市面上許多抗臭效果的機能衣,都是用功能性助劑來達到抗臭的效果,不僅會有化學添加物的健康疑慮,也有可能在洗了不到十次後,效果就會減弱!
但 KOUP 肉桂衣的抗臭能力,是來自天然的材料。透過專利技術,將天然的肉桂萃取物,與可循環再利用的寶特瓶紗結合,達到天然抗臭的效果。在戶外跑跳一整天,也不用擔心令人不愉快又尷尬的異味!
經過實驗測試,真正能有效達到抑菌效果。
▲ 抗菌測試:左圖中一點一點的都是金黃色葡萄球菌,右圖則是在接觸環保機能肉桂衣布料 18-24 小時候的反應,可以看到細菌都消失了!
也不需要擔心穿久了就漸漸沒效,經過超過 20 次、使用一年以上的實測,抗菌效果也不會減退。
▲ 經過實測,即使洗了 20 次,抗菌效果也不會減退
KOUP 肉桂衣使用特別客製化的特殊紗線,來加速排汗效果;不使用化學塗層,而是以物理性的方式來達到吸濕排汗,自然不會有效力減退的問題,洗再多次也一樣有效!
快乾效果不怕比!經臺灣紡研所測試,只要 17 分鐘就會乾!手洗也沒問題,免脫水、直接晾,不用半小時又可以再穿。多天的旅行,減輕行李負擔就靠它!
KOUP 肉桂衣使用特殊的織造技術,就像是衣服上佈滿了會呼吸的氣孔,加速排出身體在活動時產生的熱氣,穿起來涼爽不黏膩,用技術達到天然涼感(註)。
註:經實測 Q-MAX 值(瞬間接觸感溫標準)達到 0.14,符合台灣紡研所訂出的涼感紗標準。
▲ 特殊織造技術,打造涼感透氣
想盡情活動,誰也不想穿得有負擔!KOUP 肉桂衣特別挑選過材質與紡織技術,有效減少衣料重量,一件不到 100g(男生 L 號),比普通的棉 T 輕了 30% 以上,超舒服!
機能很重要,環保更不能少!你的每一個消費選擇,都能改變未來。
KOUP 肉桂衣從原料、染劑、到生產,都只選擇有環保驗證的合作夥伴,確保整個生產流程都符合環境友善最高標準。
每一件肉桂衣附上的收納袋,都是利用生產過程剩餘的布材製作而成,真正做到資源不浪費。
除此以外,肉桂衣都是以單一材料製成,因此 100% 可回收,若是哪天你穿破了、舊了、不想穿了,都可以將衣服寄回給 KOUP,讓它可以再次被製成新的紡織紗線,真正實現「循環經濟」的使命。
▲ 想了解如何回收 KOUP 肉桂衣嗎?歡迎與客服聯絡,以取得更多資訊。
一張圖看懂環保肉桂衣是怎麼製造的 ↓ ↓ ↓
不管是戶外運動、或是出門旅行,KOUP 機能肉桂衣都交出了令人滿意的成績單!
當然,穿上山更是適合不過了!來自使用者的真實好評:「肉桂衣完全不臭 好穿!」「秋季爬山穿肉桂機能衣,不用擔心羊毛太熱」。
使用者的真實好評再一枚:
「今天拿到了一件特別的機能衣,一看到名字第一個問題絕對是有沒有肉桂味。沒錯,就是來自英國的 KOUP環保機能肉桂衣。不過很可惜(?)的是,他並沒有肉桂味!
趁著好天氣穿著它去了三峽的金面山、牌子山,金牌縱走首先剪裁方面,腋下它是兩條縫線,穿著起來感覺腋下比較有空間。,即使濕了也不容易造成腋下悶熱的感覺。
而穿著起來,實測男 M 長袖僅 99g 非常輕盈,想要輕量化是個不錯選擇!
另外標榜加入肉桂抗臭,在約30度的大熱天下,走了三個半小時超會流汗且味道有時候自己也有點受不了的我,在結束行程後狂聞卻聞不到一絲汗臭,相當驚嘆,又驚喜。不用再害怕下山後要去用餐會影響到其他的客人。想必這件 KOUP 肉桂衣會是我接下來上山的必備衣服了。」
接下來,換你試試看了!
2023 夏天新色上市,清爽七色任你挑,兩件就免運囉!
黑
灰
藍
正反面分別有「K」與「KOUP」的簡約 LOGO:
全色系現貨供應中,趕快找出適合你的尺寸,挑選你這一季的舒爽顏色吧!
◆ 注意事項
1. 每台電腦螢幕因設定及廠牌不同,皆會影響顯示器的顏色呈現,難免會有色差及個人感官認知的差異,出貨以實際商品顏色為主。
2. 訂單付款確認後,將於三個工作天內安排出貨。
3. 若需退換貨,請保持商品全新、包裝完整,在七天鑑賞期內聯繫客服處理。
*KOUP 機能肉桂衣、口罩為廠商獨立出貨,請與其他商品分開結帳唷!若您的訂單內有商店內的其他商品,將導致運費計算有誤,客服會協助取消訂單,請您另外下單。造成不便,還請諒解!